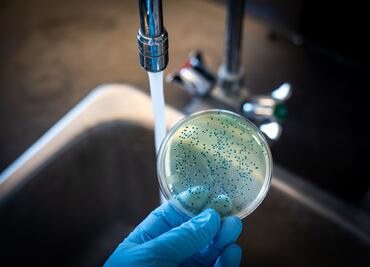

Bienestar22/09/2023
La OMS alerta de un resurgimiento de los casos globales de cólera; ¿Qué es y cómo se contagia?
La OMS advierte de que la crisis climática influye en este resurgimiento del cólera
La OMS advierte de que la crisis climática influye en este resurgimiento del cólera